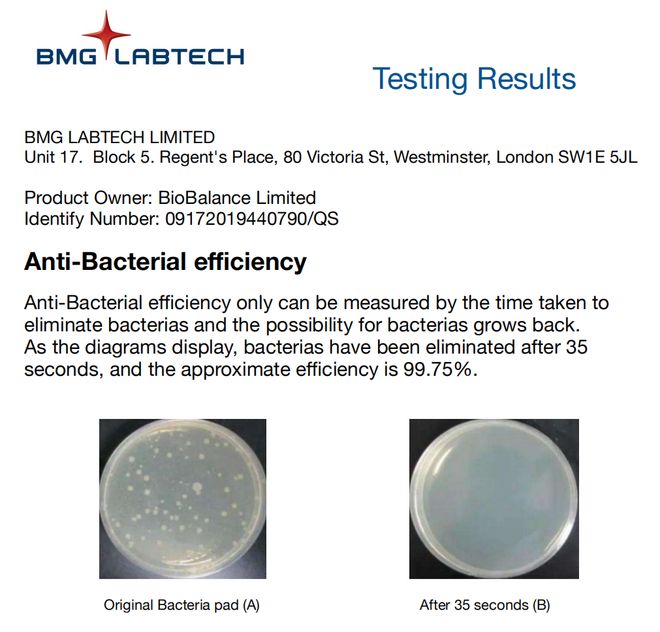

时间:2025-11-11 14:30:53
”,不停地打喷嚏,不停的擤鼻涕,纸巾用了一包又一包,最关键的是鼻子实在堵的难受啊!

经历过的人都知道,鼻子就仿佛被石头堵住,吸不进来,呼不出去,永远通不了气……


鼻子作为人体呼吸道的第一层防御机制,一旦被攻破,不仅无法起到防护机制,严重时,还可能会导致出现各种问题。

喷剂大部分都是生理盐水,作用很有限,洗鼻过程又太痛苦了,就和游泳时呛水的感觉一样,大人都忍不了,小孩子就更别提了!

小编在新西兰旅游的时候,发现一款好东西——Norvikon诺维肯苍耳油麦卢卡蜂蜜膏,经过用了一段时间后,的确还不赖!

它是由新西兰轻医药品牌Norvikon研发,使用的都是植萃成分,无激素不依赖。抹上去很清爽,很舒服,小孩也不易抗拒!

它的核心原理是抑菌,通过抑制细菌(大肠杆菌、金黄色葡萄球菌、白色念珠菌) ,作用到鼻子处,从而起到一定的作用!

不少朋友亲测,抹一抹,很舒服!当不打喷嚏也没有鼻涕的时候,感觉每一口呼吸都特别清爽顺畅!
最近发现国内有公司进口这款产品,所以特地找来了推荐给有需要的朋友,当然,也为大家争取到了优惠价:
日常价99元,现在半价优惠,1支仅需49.9元,2支89.9元,更划算!


新西兰植被覆盖高,环境特别好,但也是因为植被覆盖过高,导致花粉引起鼻子刺激的也不在少数!

也因此,新西兰对于鼻子问题的研究非常重视,Norvikon在新西兰就有专门的研发实验室及科研团队研究这一类的问题。

多名生物学专家和医学专家组成的科研团队,历时多年时间,最终利用植萃成分研发出了这款温和不刺激的苍耳油麦卢卡蜂蜜膏!

之所以推荐大家使用Norvikon这款蜂蜜膏,有很大一部分原因在于,新西兰是迄今为止世界上公认的药品生产标准非常严格的国家之一。


@Alex:被鼻子问题折磨10多年了,在用了Norvikon蜂蜜膏后,鼻子清爽了,呼吸太舒服了,发自内心的赞同和认可。

@Cynthia:好多年了,每次到了秋冬季节,鼻子真的非常难受,用了Norvikon蜂蜜膏后,鼻子像打开了新世界的大门,这感觉太奇妙了!
Norvikon研发团队开创了独有的护鼻配方,选用了新西兰独有的麦卢卡蜂蜜UMF10+。

UMF10+麦卢卡蜂蜜可称得上新西兰的“国宝”,因为其优异的抑菌作用,运用比较广泛。


抑菌效果具体有多强呢?欧洲权威机构BMG曾验证:麦卢卡蜂蜜UMF10+的抑菌效果达到了99.75%!
另外,Norvikon蜂蜜膏这款产品我们也单独做了抑菌效果检测:其抑菌效果也高达99%!

所以,你在使用它过后会明显的感受到清爽了不少,就是因为鼻腔里的一些细菌被抑制,减少了对鼻腔的刺激。


Norvikon研发团队曾调研到,澳洲大陆的土著,甚至动物都会食用一种天然的植物——尤加利。

进一步研究后发现,尤加利中含有的桉油醇, 桉油醇量越高,作用就越好,Norvikon采用超临界C02的工艺方法,精炼出高纯度的桉油醇,滋润通畅鼻腔!

此外,“苍耳”这种植物,《本草纲目》记载具有疏风通窍的效果,意大利人种植后发现这种植物也能够作用在鼻腔上,随即流传至今。

团队发现后,将苍耳油和尤加利相结合,为了达到很好的使用效果,采用前沿的小分子渗透技术,涂抹后,能快速进入鼻腔内部,清爽鼻腔,给鼻子一个舒适的环境。

使用后可能会短暂出现黄鼻涕的现象,那是鼻腔中的垃圾被清除的表现,鼻腔变得干净、通畅,呼吸自然顺畅。
使用方法很简单,旋转打开后,对着鼻腔轻轻涂抹几下即可,瞬间就感觉舒服了!

出门在外,不管是上学、上班,鼻子不舒服了,涂抹几下,鼻子清爽舒畅,不影响工作和学习!
鼻子不舒服了抹一抹,1支3.5g,看似很少,一天抹上2~6次,可以抹好久,使用简单效果还不错!

进口产品还蛮贵的,市场价一支就接近百元了,不过这次小编特地给大家争取了优惠价:
1支仅需49.9元,2支89.9元,活动产品,数量有限,有需求的朋友需要尽快下单!

*本品属于日常个护产品,不具有医疗功效,具体使用效果因人而异,建议有病症情况及时就医处理。